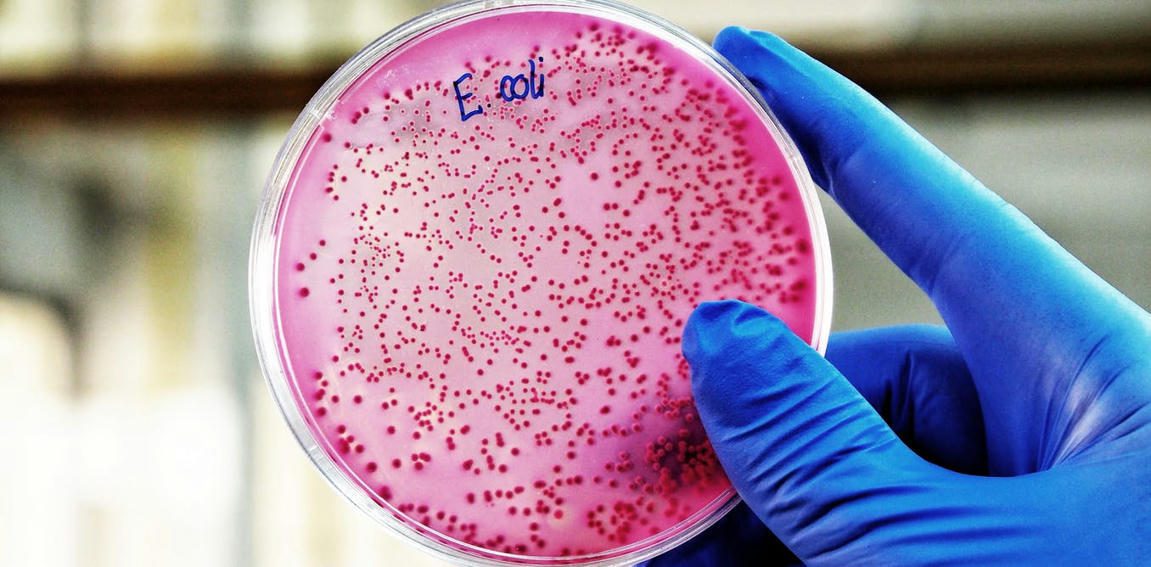

Aliments contaminés par la bactérie ‘E. coli’ : quels effets sur la santé et comment prévenir les infections ?
Les récentes intoxications alimentaires par la bactérie E. coli ont rappelé les risques liés à la consommation d’aliments contaminés. D’où viennent ces risques ? Quels sont-ils ? Comment les éviter ?
Lire l’article complet sur : theconversation.com